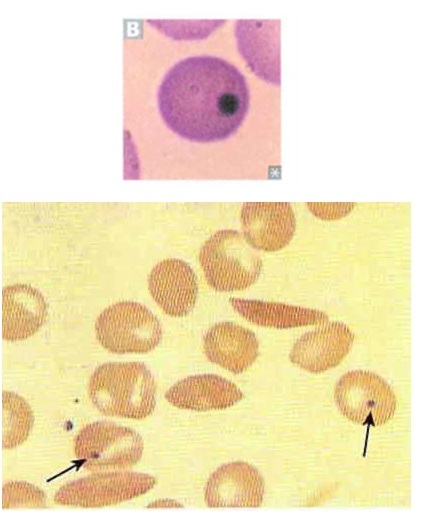
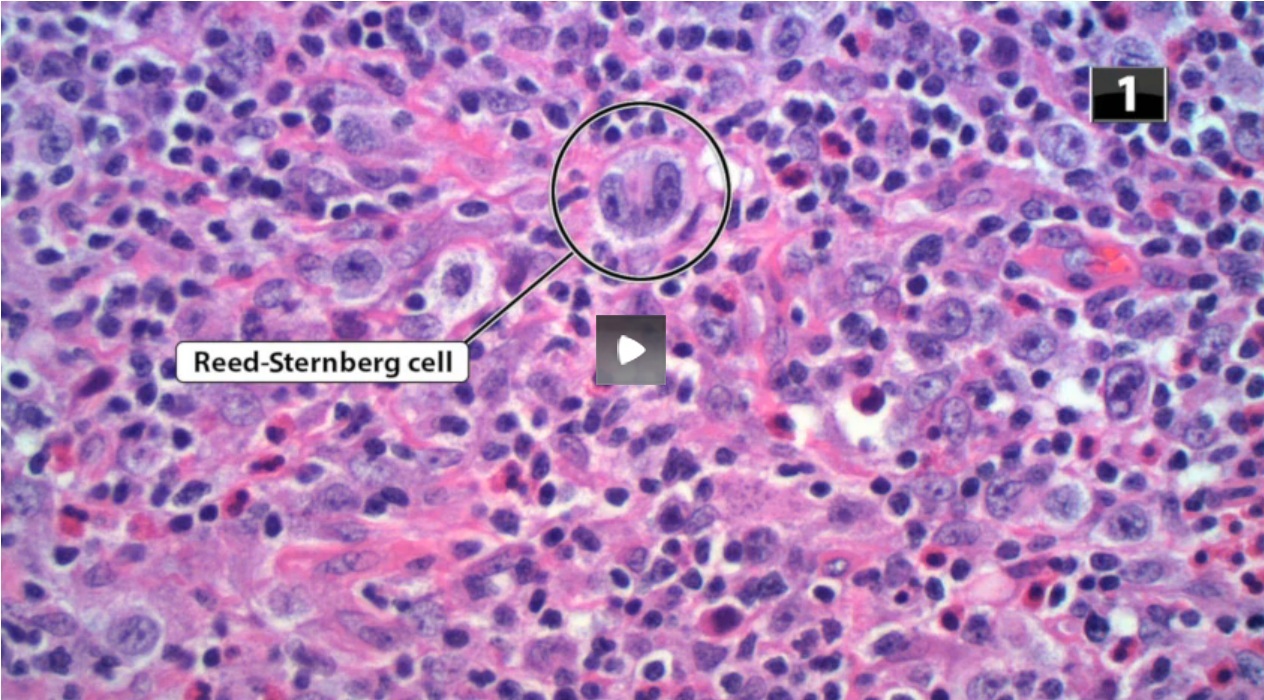

What medications are commonly used in the treatment of mild-moderate Crohn disease in adults?
COIN B for Crohn
Conventional glucocorticoids (Prednisone) ± antibiotics (Ciprofloxacin, metronidazole) for acute exacerbations
Oral 5-aminosalicylates (ASA agents) (mesalamine, sulfasalazine) - initial therapy for mild disease
Immunomodulators - Azathioprine or mercaptopurine > methotrexate
Non-systemic glucocorticoids - Budesonide
Biologic therapies - Anti-TNF agents (infliximab, adalimumab)
A 60-year-old man is evaluated for an enlarged prostate. How does flutamide differ from finasteride in relation to mechanism of action and clinical use?
Flutamide - Used in prostate cancer, non-steroidal competitive inhibitor of androgens
Finasteride - Used in BPH, inhibits 5α reductase, which converts testosterone to dihydrotestosterone (DHT), Used for male-pattern baldness
Which bacteria are most commonly responsible for sialadenitis? What condition most commonly predisposes a patient to sialadenitis?
- S. Aureus
- S. Viridans
- S. Mutans
Due to Sialolithiasis (stone obstruction of the salivary gland duct)
A 37-year-old man is fasting for religious reasons. What energy metabolites does the liver secrete in the fed state vs. in the fasting state?
- Fed state - Insulin stimulates the storage of glycogen, lipids, protein
- Fasting state - Blood glucose is maintained by glycogenolysis, gluconeogenesis, ketone bodies are released
A 23-year-old man undergoes a splenectomy due to splenic rupture from blunt abdominal trauma. What would you expect to find on this patient’s peripheral RBC smear after the splenectomy? Asplenic patients are susceptible to which encapsulated organisms? What vaccines for these encapsulated organisms should be given to asplenic patients?
Howell-Jolly bodies - Basophilic nuclear remnants found in RBCs
“Some Killers Have Nice Shiny Bodies”
Streptococcus pneumoniae
Klebsiella pneumoniae .
Haemophilus ¡influenzae type B
Neisseria meningitidis
Salmonella
Group B Strep
“Give SHiN vaccine”
Vaccines - Give S. pneumonia, H. influenza, N. Meningitis (Capsule, conjugated with a protein, serves as antigen in vaccines)
A 65-year-old woman with COPD is in severe respiratory distress, has cyanosis and signs of right-sided heart failure. What medications are used in the treatment of pulmonary hypertension? What is its mechanism of action?
Cor pulmonale due to COPD induced pulmonary hypertension
Pulmonary Hypertension Treatment:
All of these agents cause vasodilitation -
- (1) Endothelin-1 antagonists: Bosentan, Ambrisentan;
- (2) Prostaglandin analog (Iloprost, epoprostenol (vasodilate pulmonary vasculature);
- (3) cGMP phosphodiesterase inhibitors (Vardenafil, Tadalafil, Sildenafil (Revatio);
- (4) Dihydropyridine CCB (Nifedipine, amlodipine)
A 56-year-old man develops right lower extremity edema after a returning from Europe from a business trip. An exam of the right lower extremity demonstrates a red, warm, lower leg with a positive Homan’s sign.
What is the patient’s diagnosis?
What is a positive Homan’s sign?
What is Virchow’s triad?
What is the most common inherited hypercoagulability syndrome?
Deep venous thrombosis
Homan’s sign - Pain in the calf muscle upon dorsiflexion of the foot (Not very sensitivity 60-88%, NOT Specific for DVT: specificity 30-70%)
Virchow’s triad
- Stasis
- Hypercoagulability
- Endothelial damage
Factor V Leiden - Clotting factor V cannot be degraded by protein C resulting in an inability for protein C to control clotting cascade
A 45-year-old white woman presents with a 1cm x 1cm, painless, mobile mass in her right parotid gland. You inform the patient that most tumors in the parotid gland are benign.
What is the most common benign tumor of the salivary gland?
What is a Warthin’s tumor?
What cranial nerve goes through the parotid gland?
- Most common - Pleomorphic adenoma
- Warthin’s tumor - Benign, heterotopic salivary gland tissue trapped in a lymph node
- CN VII
Choose the most appropriate therapy:
A 22-year-old man with drug-resistant gonorrheal urethritis
Ceftriaxone
Choose the most appropriate therapy: Lyme disease treatment
Tetracycline
Choose the most appropriate therapy: UTI prophylaxis for a 44-year-old woman with a history of recurrent UTIs
- TMP-SMX
- Nitrofurantoin
- 1st or 2nd generation Cephalosporin
- Amoxicillin
Choose the most appropriate therapy: A 33-year-old hiker with Giardia lamblia
Metronidazole
Choose the most appropriate therapy: A 23-year-old woman with antibiotic-induced C. difficile colitis
Metronidazole - most often used
Oral Vancomycin
A 44-year-old male hepatitis C patient is undergoing recombinant interferon treatment for his disease. In what ways do interferons interfere with viral protein synthesis?
Interferons induce cellular antiviral defenses:
- RNA protein kinase (ribonuclease that degrades viral mRNA but not host mRNA),
- Pro-apoptotic pathways
You are reading a research article about the prostate specific antigen test, and it mentions that the PSA blood test is associated with a high false positive frequency. In your own words, explain what false positive means.
Test is positive even though disease is not present
A 25-year-old woman presents to clinic with scanning speech, intention tremor, intermittent incontinence, and internuclear ophthalmoplegia. What is internuclear ophthalmoplegia?
Internuclear opthalmoplegia - Classic for MS, but possible stroke in elderly patient
- Lesion in medial longitudinal fasciculus
- Medial rectus palsy on attempted lateral gaze
- Nystagmus in abducting eye
- Convergence is normal
What effect does stress have on adipocytes?
- Sympathetic activation –> Epi and NE
Activates hormone-sensitive triglyceride lipase in fat cells Rapid breakdown of triglycerides, and mobilization of fatty acids
2.Corticotropin release from anterior pituitary
Adrenal cortex secretes more glucocorticoids
Stimulates lipase in fat cells
You are seeing a 54-year-old man six months after a percutaneous coronary intervention for an anterior myocardial infarction. Consequently, the patient was placed on aspirin 81 mg per day, atorvastatin 20 mg per day, and atenolol 100 mg twice a day. The patient reports feeling better but has been bothered by difficulty with achieving and sustaining an erection.
What would be a common reason for this patient’s erectile dysfunction?
What are the common side effects of β-blockers?
Which patient populations should use caution when taking β-blockers?
Adverse effect of atenolol
Atherosclerosis of the arteries supplying the penis
Fear of a heart attack
SE of beta blockers:
- Impotence
- Exacerbation of asthma
- Bradycardia, AV block
- CHF
- Sedation, sleep alterations
Take caution:
- Diabetics
- Asthma
- Bradycardia or AV block (if on verapamil or diltiazem, may get full block)
- Acute CHF
A 5-year-old boy is treated with mebendazole for a pinworm infection. Mebendazole acts on microtubules to inhibit the helminthic infection.
What other medications act on microtubules?
What syndrome demonstrates a defect in microtubule polymerization?
Griseofulvin - antifungal
Vincristine
Vinblastine
Paclitaxel
Colchicine
Chédiak-Higashi syndrome - deficiency of phagocytosis (macrophages have poor microtubule function)
A 33-year-old man is diagnosed with Hodgkin lymphoma and treated with doxorubicin, bleomycin, vincristine, cyclophosphamide and etoposide. While undergoing treatment, the patient develops a paralytic ileus and neurotoxicity from the treatment regimen.
Which chemotherapy agent most likely is the cause of these sequelae?
What is the characteristic pathology finding of Hodgkin lymphoma?
Doxorubicin - cardiotoxicity
Bleomycin - pulmonary fibrosis
Vincristine - neurotoxicity - leading to a peripheral neuropathy
Cyclophosphamide - hemorrhagic cystitis
Etoposide - bone marrow suppression
Reed-Sternberg cell: multiple or bi-lobed nuclei, owl eye appearance, shrink so clear area surrounding the cell.
These cells are also Positive for B cells CD30 and CD15
Alkylates DNA, toxicity –> pulmonary fibrosis
Busulfan
Fragments DNA, toxicity –> pulmonary fibrosis
Bleomycin
Cross-links DNA, nephrotoxic, ototoxic
Cisplatin, Carboplatin, Oxaliplatin
Nitrogen mustard, alkylates DNA (electrophile that binds DNA)
Cyclophosphamide



